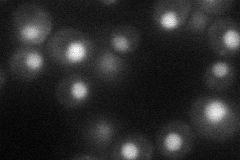
YDR386W
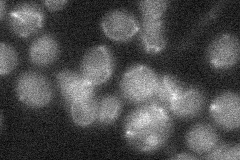
YDR386W
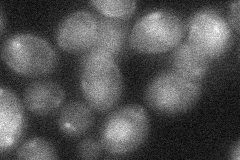
YDR386W
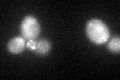
YDR386W
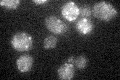
YDR386W

View description
Subunit of the structure-specific Mms4p-Mus81p endonuclease that cleaves branched DNA; involved in DNA repair, replication fork stability, and joint molecule formation/resolution during meiotic recombination; helix-hairpin-helix protein
Localization:
Intensity:
Fold change:
Significance:
-
C’ GFP library in SD

cytosol22.17 -
N' NOP1pr-GFP in SD
nucleus36.2717 -
N' TEF2pr-mCherry in SD

nucleus17.9713 -
N' NATIVEpr-GFP in SD
punctate19.905 -
N' TEF2pr-VC and Cyto-VN in SD
below threshold24.9279 -
C’ GFP library in SD+DTT
cytosol30.111.35Yes -
C’ GFP library in SD+H2O2

cytosol28.421.28No -
C’ GFP library in Starvation Media
cytosol24.191.09No -
C’ GFP library on the background of Pup2-DaMP

cytosol -
C’ GFP library on the background of CCT mutant

cytosol21.9240.988533No
